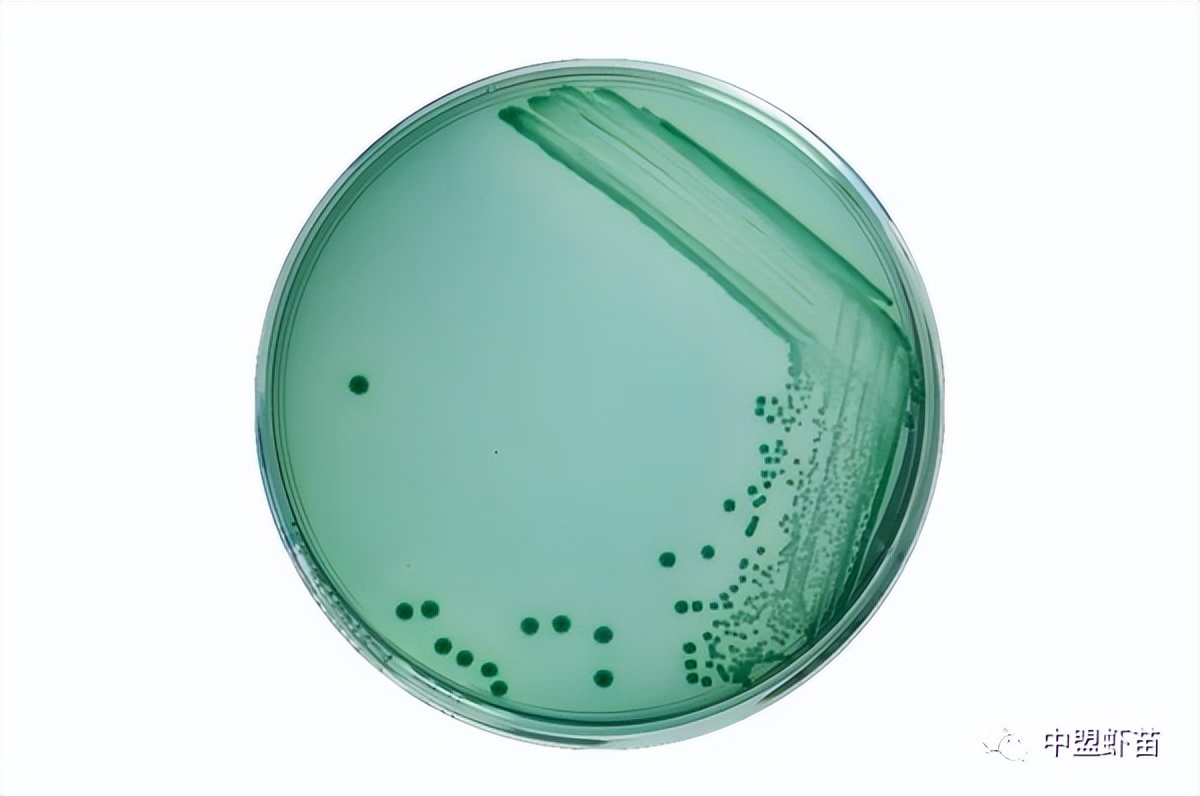
这种虾病，对虾产业产生深远影响！养殖大神揭露该病的今生前世！
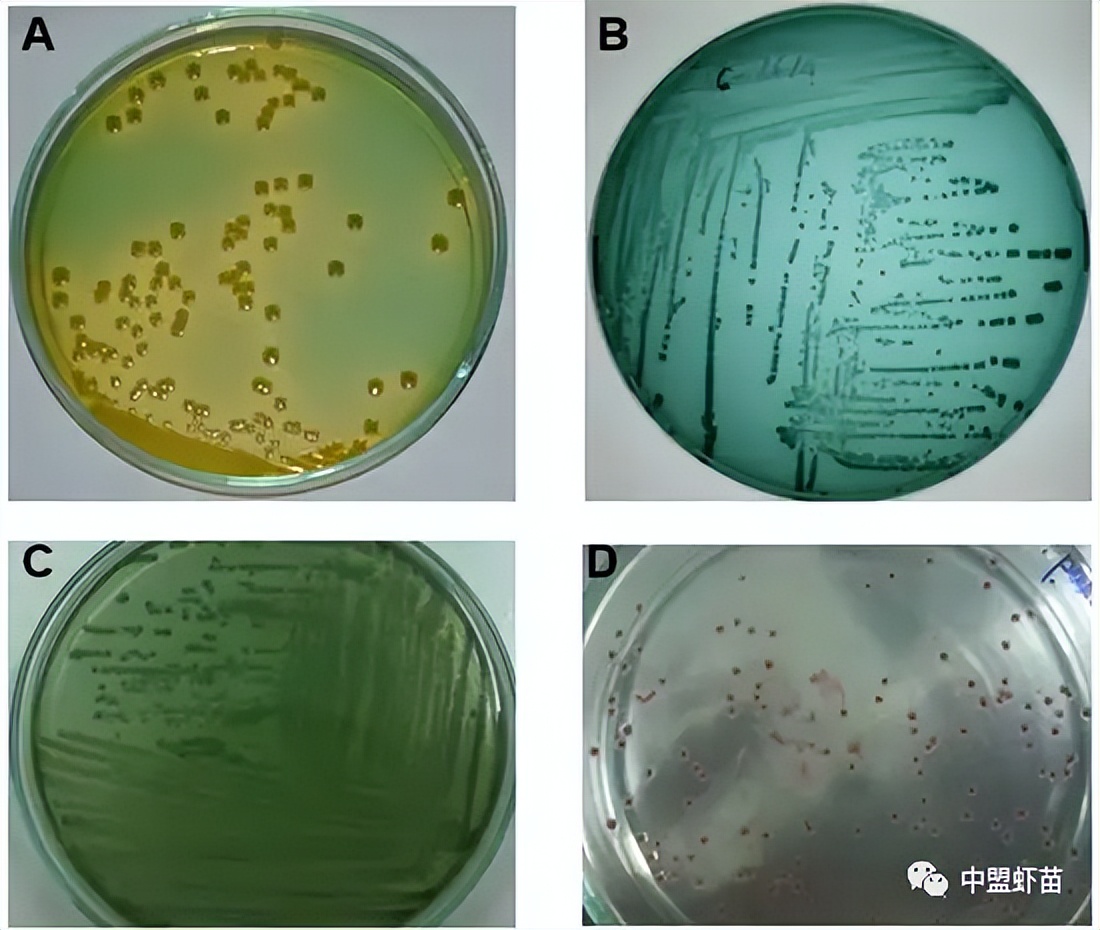
这种虾病，对虾产业产生深远影响！养殖大神揭露该病的今生前世！

前言:

全球65%的虾产量集中在亚洲,其中以东南亚为重点。该地区虾类生产的主要国家有越南、泰国、印度尼西亚、马来西亚,以及中国和印度(亚洲)。
其中,养虾产量大部分来自南美白对虾,其余为斑节对虾。斑节对虾主要养殖在越南和印度。其余的是白对虾养殖,主要集中在泰国、印度尼西亚和中国。
近年来,对虾白变病(White Feces Syndrome - WFS)主要发生在超集约化南美白对虾养殖场(尤其是高密度白对虾养殖)。

出现白便病的虾池
那么什么是对虾白便病呢?就让通过下面的文章,来了解一下白便病的起源,以及防治虾白便病的方法。

一、对虾白便病的起源

虾类白便病自大约2000年代以来就已被发现和报道,被认为是全世界对虾养殖、特别是南美白对虾养殖面临的极其严重的问题之一。南美白对虾和斑节对虾均可患白便病,但南美白对虾白便病的发病率,通常高于斑节对虾虾。
据悉,白便病首先在泰国超密集南美白对虾养殖场暴发,当时正是寒冷季节刚结束,温度上升时期。
另外,厄尔尼诺现象导致天气异常炎热,导致全球气温上升,导致养虾场池塘水温上升(由32℃增至34℃),与南美白对虾的最适温度条件相比(从28℃到30℃)还要高。

厄尔尼诺现象对全球的影响
经历了这样一个气温升高的过程,养殖户开始看到虾出现了摄食异常,虾的肠道发生了严重的变化,池塘里出现了白色的粪便,虾逐渐衰弱而死亡。
在越南,白便病在2000年代初就开始出现,当时还没有超集约化养虾的概念。另外,中部地区的精养和半精养斑节对虾池塘已经开始遭遇白便,尽管池塘主人在投苗前精心整改了池塘,并对水源进行了处理,但是,还是不能完全杜绝该疾病。

尽管池塘已经非常仔细地处理,但白便病仍然发生,请问是什么原因造成的呢?
渐渐地,对虾白便病也蔓延到西部省份的养虾区。后来,养殖户开始升级对虾养殖模式,从半精养、精养到超精养,从中开始遇到更多的白便病。当全国虾农转向超集约化南美白对虾养殖时,白便病(白便综合症 - WFS)对虾造成的损害越来越严重。
曾经有很多虾农采用了很多方法来控制和治疗白便病,但都没有成功。结果,虾开始慢慢死亡,虾农被迫提前收获,以避免过度损失。
经历了多起白便病事件,科学家找到了根源,从而为白便病提供了最有效的预防和治疗方案。

二、虾白便病(白便综合症-WFS)的原因

多年来,世界各地的科学家一直在对虾白粪病进行研究。通过对患有白便病的虾样本进行调查、肝胰腺和肠道检测,科学家发现了与白便病直接相关的原虫(Gregarine)。此外,科学家还在感染白便病的虾的血浆、肠道和肝胰腺中发现了非常大量的细菌,这种细菌是弧菌属。
在白便虾血浆中检出的细菌,包括:创伤弧菌(80%)、河弧菌(44%)、副溶血弧菌(28%)、溶藻弧菌(20%)、哈维氏弧菌(18%)、微小弧菌 (8%) 和霍乱弧菌 (6%)。肝胰腺中只检测到少量的聚脂物质,并检测到大量的微孢子虫(EHP)。
另外,池塘藻类特别是有害有毒藻类的暴发,也是引发对虾白便病的主要原因。这些藻类体积很小,虾是杂食动物,很容易误食有毒藻类,引起虾的肠道疾病。
病原体攻击肝胰和肠道系统,损害和降低这些器官的功能,导致虾无法吸收饲料,同时受到病原体的攻击,是虾死亡的另一个机会。
观察病虾的肝胰系统,肝胰管内的上皮细胞脱落,然后在聚集在肝胰、胃、中肠交界处,然后被排出体外。
对虾白便的分析表明,其成分主要是脂质、肝胰腺和肠道系统的一些结构,并且经常发现幼虫以及蠕形虫的尸体。它也被确定为白便病的病原体之一(Sriurairatana et al,2014年)。
此外,虾的肝胰腺、肠道和粪便中存在高浓度的细菌群,属于:副溶血弧菌、河流弧菌、溶藻弧菌、拟态弧菌、创伤弧菌、霍乱弧菌和达姆塞拉弧菌(Limsuwan et al,2010年)。
2010年,Ha组等人的白便病病因报告发现,对虾微孢子虫(EHP)是白便病的病原体。
综上所述,引起对虾白便病(White Feces Syndrome - WFS)的主要原因有:
①、 有害藻类过度爆发。
②、霉菌的存在(通常是使用变质、发霉或质量差的饲料)。
③、 寄生虫(Gregarine)的入侵。
④、 肝胰管上皮细胞脱落。
⑤、 对虾微孢子虫(EHP)入侵。
⑥、 在池塘水中,弧菌爆发。
因此,想要预防和彻底治疗白便病,就必须了解白便病的病因,才能制定最准确的治疗方案。
1、有毒藻类、有害藻类引起的白便病
引起对虾白便病的有毒有害藻类,有:蓝绿藻、甲藻、眼藻等藻类。这些藻类分泌多种毒素,例如:
①肝毒素: 攻击虾的肝脏,削弱肝脏功能,为弧菌的繁殖创造了条件,对虾的肝胰腺、肠道和整个内脏造成严重损害。
②神经毒素: 作为肌肉活动中枢,尤其是鳃区肌肉活动的主要因子,使虾瘫痪,无法呼吸(或呼吸困难),导致虾体虚弱,增加受到弧菌攻击的机会。
③细胞毒素: 攻击和阻断细胞,特别是免疫细胞的活性,使虾的免疫系统减弱,失去对抗能力,为弧菌创造攻击机会。
④蓝藻毒素: 这是蓝细菌(cyanobacteria)的特定毒性群。在这组毒素中充满了能够攻击肝脏、神经系统和消化系统的毒素。
(*)注:肝毒素、神经毒素、细胞毒素、蓝藻毒素是一组毒素的名称(不是某种毒素的名称),在每个毒素组中,每种毒藻都会分泌一种单独的毒素,并且每种毒素都会具有相同的毒性。攻击和毒性机制。例如,Cylindrospermopsins和Lyngbyatoxin-a是属于蓝藻毒素组的两种毒素,这两种毒素主要攻击虾的肝脏和消化系统(胃、肠)。

虾被有毒藻类攻击
此外,有毒有害藻类还会分泌能够麻痹肠道细胞组织的酶,使虾肠道无法吸收饲料和营养物质。导致虾不能消化饲料,造成虾肠道堵塞,引起虾白便病。
2、霉菌引起的白便病
霉菌也是引起白便病的常见原因之一。一般情况下,霉菌不会出现在虾池中,而是出现在虾饲料中。
如果虾饲料保存不好,或者使用劣质饲料,就会发生霉菌。如果处理不当,而是直接喂虾,会非常危险。

虾的肝脏受到霉菌毒素群的攻击而严重受损,从而导致虾的整个消化系统遭到破坏。
当虾吃了发霉的食物后,霉菌就会进入虾的肠道。霉菌还会分泌抑制肠道的毒素(类似毒藻、有害藻类)并改变消化酶(如脂肪酶和淀粉酶),从而导致虾出现白便病。
3、由寄生虫(Gregarine)引起的白便病
Gregarine,由前细胞(P:Protomerite)和后细胞(D:Deutomerite)组成。前细胞和后细胞都具有细胞核,其结构在显微镜(放大倍数100至400倍)下观察时非常明显。

对虾肠道进行显微镜检查,发现Gregarine寄生虫茧和成Gregarine寄生虫成虫
Gregarine的前细胞在头部有一个附着物(E:Epimerite),这有助于Gregarine附着在虾肠的上皮细胞上。这是引起对虾肠道疾病,特别是白便病的核心因素。

对虾白粪病的总体症状:(a):池塘上漂浮着一串白便;(b):料台中出现白色粪便(嗅/蹄);(c) 虾肠道内出现米粒状物质;(d) 虾肠道内的Gregarin寄生虫;(e) 感染寄生虫的虾肠;(f) 虾开始死亡。
4、肝胰管上皮细胞转化、脱落引起的白便病
当出现白色粪便时,虾肠内会充满白色至黄色粪便,并肿胀。在显微镜下,观察到许多“异物”伴随着聚居寄生虫的出现。
高达96%的感染白便的虾,肝胰腺中含有许多这些“异物”。在受感染的池塘中,与正常池塘相比,存活率降低20-30%。

在肝胰腺和肠道内容物中发现了蠕虫状孢子或Gregarine样寄生虫。
经过大量的研究和检验,科学家们将这种“异物”命名为Vermiform。这是一个英语科学术语,由拉丁词根vermes组成,意思是蠕虫和正在形成的形式。
因此,蠕虫是一个“物体”而不是一个活的有机体。尽管它的外表像蠕虫,但它不是有机体,也不是寄生虫,蠕虫只是一个物体。
具体来说,蠕虫无法移动,并且缺乏构成身体的细胞器。它们含有许多从肝胰腺脱落的薄层,源自上皮细胞的微绒毛。但与寄生虫的结构完全不同。蠕虫状形成的原因目前尚不清楚,但蠕虫状形成是由于微绒毛的丧失和随后的细胞裂解造成的,表明这是一个病理过程(Sriurairatana et al., 2014)。

肝胰腺 (HP) 组织H&E染色切片中的ATM合成步骤与真正的Gregarine寄生虫进行比较。
蠕虫的存在,会影响养殖虾营养物质的消化和吸收。同时,成活率降低,对虾生长缓慢,易受细菌、病毒等条件致病菌的侵害。
在严重的情况下,大量的蠕形虫会导致白便病的形成,这与引起虾白便病(白便综合症 - WFS)的机会病原体有关。
5、微孢子虫(EHP)引起的白便病
EHP于2009年在泰国首次检测到,并在斑节对虾上发现该病原体。

感染EHP的虾
微孢子虫(EHP)是一种在垂直和水平传播中传播速度非常快的疾病。在产卵过程中,亲虾也会传染给虾苗。此外,虾还会因处于有病原体的环境或者摄食带有病原体的饲料,而导致发病。

健康虾肝样本 (A) 和感染 EHP 的虾样本 (B)
感染EHP的虾的主要临床症状,是:生长迟缓。在更加严重的阶段,感染EHP的虾通常会出现软壳、食欲下降和空肠的情况。
感染EHP的虾没有典型的病症,感染EHP的虾在投苗约25天后通常大小不均匀。与未受感染池塘中的虾相比,虾的生长速度仅为10%-40%。

A.肝胰腺结构正常;B. 孢子出现和肝胰腺脱落;C. 肝胰管解剖;D. 严重的细胞损伤
此外,感染白便综合症(WFS)的虾池中也经常检测到EHP,感染率高达96%,生长迟缓综合症(MSGS)的感染率约为55.5%。
根据对虾白便病相关的差异,科学家们在世界上两个不同的地区——东南亚和拉丁美洲,进行了系统研究,以确定白便病与EHP疾病之间的关系。这些研究是在一个有白便病 (WFS) 病史,且因EHP感染导致生长迟缓的亚洲国家进行的。从感染WFS和未感染WFS的池收集样本。收集肝脏和粪便样本并进行组织学分析并进行定量PCR检测 (qPCR)。

具有WFS病症的虾样本(左上);观察到胃肠道出现白色病变(右);
通过定量PCR (qPCR) 单独分析每个池塘虾的肝胰腺组织。结果表明,含有EHP的虾组中的白便迹象,比未感染WFS的池塘中的虾要高。这表明患有白便病的虾更容易感染EHP。
从以上研究来看,WFS与EHP之间存在着非常密切的关系。此外,科学家们还发现养成池中的WFS、EHP和SHPN(肝胰腺坏死)之间存在关联,这表明WFS可能是虾体内的一种生理反应,受到肠道病原体和EHP的共同影响。

白便病的主要原因(弧菌属,机会性菌株)和环境因素的结合,可引起EHP流行地区的白便病
综上所述,微孢子虫(EHP)可能不是对虾白便病(白便综合症-WFS)的直接原因,而是EHP引起的后果(软壳、食欲下降、空肠)促进弧菌菌株。是造成对虾白粪病的直接原因。
6、由弧菌引起的白便病。
在白便病的病因中,弧菌是一种常见病原体,在感染白便病的虾中,感染率超过40%。
TCBS培养基上弧菌属。
这种细菌非常聪明,因为它们对抗生素的耐药性高达73%,而且会分泌生物膜来帮助粘附在虾的肠壁上,这种膜化合物被称为胞外多糖,让细菌能够保护自己。一旦保证了自己的安全,弧菌属就可以会不断繁殖,分泌毒素,引起虾体软壳或肠胃萎缩,导致虾体大量死亡。它们还可以附着在甲壳类动物、水生动物等上,影响下一造虾。
但它们有一个弱点, 那就是不能形成孢子,通过鞭毛移动。这两个因素,如果我们了解一点微生物原理的话,是有很大限制的。
越南芹苴大学渔业系的一项研究确定了弧菌引起白便病的能力。在湄公河三角洲的一些省份从南美白对虾(Litopenaeus vannamei)中分离出来。
实验确定在5个不同的细菌组合上进行的组合能力,包括:
ACV = 溶藻弧菌、霍乱弧菌和创伤弧菌;
ACP = 溶藻弧菌、霍乱弧菌和副溶血弧菌;
AVP = 溶藻弧菌、创伤弧菌和副溶血弧菌;
CVP = 霍乱弧菌、创伤弧菌和副溶血弧菌;
ACVP = 溶藻弧菌、霍乱弧菌、创伤弧菌和副溶血弧菌;
实验监测:处理每天进行排污、换水并监测水质指标。连续观察14天对虾的病理体征和表达情况。收集所有刚刚死亡或活力下降的虾,记录病原菌出现时间、发病症状和死亡率。
对细菌组合实验的监测结果表明,实验期间阴性对照组中对虾的存活率为100%,所有处理组均因细菌感染而死亡,随着死亡发生时间的不同,不同组合的死亡率也不同。
从实验中的死亡率结果来看,弧菌组合的影响。从大至小分别为ACVP < ACP < ACV < AVP < CVP。

关于南美白对虾确定弧菌属组合致病性的结果表。(来源:越南农业科技杂志 – No. 08(129/2021))
选择性培养基弧菌菌落形态。A:TCBS培养基上霍乱弧菌菌落;B:TCBS培养基上副溶血弧菌的菌落;C:TCBS培养基上创伤弧菌的菌落;D:TSAT培养基上副溶血弧菌的菌落。
单一品种的弧菌感染,对虾没有表现出白便病的临床症状,但感染溶藻弧菌和霍乱弧菌则出现拉稀、肝胰腺肿胀的症状,创伤弧菌和副溶血弧菌主要影响肝胰腺,导致颜色苍白、肿胀或萎缩。
感染溶藻弧菌、霍乱弧菌、副溶血弧菌和溶藻弧菌、霍乱弧菌、创伤弧菌组合的虾,表现出与野生池塘白便病虾相似的病理症状。

三、结论

总之,弧菌是虾白便病(白便综合症 - WFS)的主要原因。它们侵入、破坏肠道菌群,并攻击虾的器官,从而导致虾患病。然而,虾本身也对弧菌有抵抗力。这是因为虾的免疫系统也具有发现并消灭这些病原菌的功能。除非弧菌的密度太大,虾无法应对,导致它们侵入并攻击虾。
另外,有毒藻类、霉菌、Gregarines、Vermiform、EHP等虽然不直接引起对虾白便病,但对引起对虾白粪病的过程影响很大。具体来说,有毒藻类、霉菌等会分泌毒素,破坏和削弱虾的内脏和全身,为弧菌的繁殖创造条件。趁机发作并引起白便病。
而Gregarines、Vermiform、EHP等会寄生或存在于虾的器官系统中,耗尽虾的营养,削弱虾的体质,从而为弧菌的繁殖创造条件。趁机发作并引起白便病。
当能够准确识别白便病的病因后,人们就可以选择合适的白便治疗方案,采取措施预防和彻底处理对虾白粪病(白粪综合症——WFS)。

四、对虾白便病防治方案

① 投苗前彻底处理池塘。
② 水源在供应到池塘进行养殖之前,需要用强化学物质进行处理,以消除寄生虫和致病细菌。
③ 对于虾池,虾农应使用对虾安全的消毒剂进行处理,注意,此时虾体较弱,限制强效杀菌剂的使用会对虾体造成影响。
④ 控制虾的摄食量,不要给虾过量投喂,因此,虾农需要准确估算和计算虾的成活率,并根据虾的平均重量百分比确定具体的饲料用量。
⑤ 池塘中的溶解氧含量应保持在较高且稳定的水平,至少在5ppm以上。
⑥ 经常使用芽孢杆菌等益生菌,来维护池塘环境的稳定。